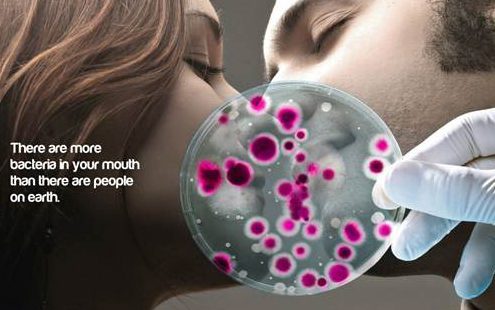
hôn nhau có bị lây sâu răng hay không 2

Hôn nhau có bị lây sâu răng hay không có lẽ là câu hỏi được nhiều cặp đôi quan tâm nhất vì đây là một hoạt động trao đổi của nước bọt giữa hai bên, cũng là môi trường thích hợp của nhiều loại vi khuẩn, virus cũng là nguyên nhân lây bệnh.

Một số bệnh lây truyền qua đường hô hấp như bệnh cúm, quai bị, sốt rubella, thủy đậu, bệnh lao phổi … sẽ dễ dàng bị lây vì virus gây bệnh sẵn có trong nước bọt. Nếu bạn cũng quan tâm tới vấn đề này, hãy cùng nha khoa Đông Nam tìm hiểu câu trả lời trong bài viết dưới đây nhé!
1. Hôn nhau có bị lây sâu răng hay không
Có lẽ bạn đã từng được khuyên hạn chế tiếp xúc với những người bị cúm, vì khi ho hoặc hắt hơi họ có thể truyền vi trùng qua cho bạn. Nhưng chắc chắn bạn không hề lo lắng hay suy nghĩ đến việc hôn nhau cũng có thể lây nhiễm bệnh sâu răng.
Sự thật là khi hai người hôn nhau, nụ hôn càng nồng nhiệt, càng lâu thì càng giúp cho vi khuẩn sâu răng “du lịch” dễ dàng hơn.

Cũng giống vi khuẩn cảm cúm thông thường, những vi khuẩn gây sâu răng có thể dễ dàng xâm nhập vào miệng thông qua hôn nhau.
Tiến sĩ Layliev nói rằng sâu răng được truyền qua tiếp xúc miệng tới miệng khi có sự trao đổi nước bọt. Chỉ cần nghĩ lượng nước bọt mà bạn tiếp nhận từ đối tác bao nhiêu thì có nghĩa bạn đã rước vào miệng mình bấy nhiêu vi khuẩn.
Năm 1993, Viện nha khoa thuộc ĐH Helsinki ở Phần Lan đã nghiên cứu 4 cặp vợ chồng, và phát hiện cứ một người bị sâu răng, người còn lại chắc chắn sẽ lây bệnh sâu răng. Thủ phạm gây sâu răng là vi khuẩn liên cầu có tên khoa học là Mutans. Mutans rất phổ biển và đặc biệt di chuyển dễ dàng.

2. Phải làm sao để hạn chế sâu răng sau khi hôn?
Nếu chẳng may lỡ có tình cảm với người thường xuyên bị đau khi sâu răng. Trong trường hợp này, bạn nên thuyết phục đối phương đánh răng trước khi cả hai “khóa môi”.
Nếu phương án này không thực hiện được, bạn hãy cố gắng đánh răng và làm sạch kẽ răng sau khi hôn nhau, có như vậy mới loại bỏ thật sạch các loại vi khuẩn có hại.

Bạn có biết một nụ hôn có thể giúp truyền 278 loại vi khuẩn cho người mình yêu. Khoảng thời gian hôn nhau đủ để truyền 10.000 con vi khuẩn sang đối phương và ngược lại.
Đó chính là lý do vì sao chỉ nên hôn người mà bạn đã biết rõ và hãy cùng nhau có chế độ chăm sóc răng miệng thật tốt để nụ hôn luôn ngọt ngào nhé!
Xem thêm sâu răng:
- Chi phí nhổ răng sâu giá bao nhiêu?
- Trám răng bị sâu bao nhiêu tiền?
- Quy trình trám răng sâu chuẩn nhất hiện nay
- Chữa sâu răng bằng lá lốt
- Sự thật về con sâu ở trong răng
